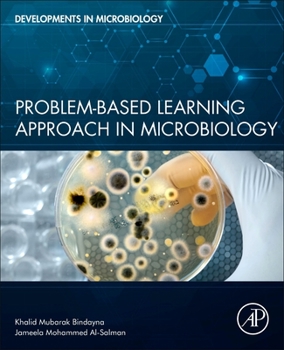
Paperback Problem-Based Learning Approach in Microbiology Book

Problem-Based Learning Approach in Microbiology
Problem-based Learning Approach in Microbiology, is an organ-based study of microbiology and infectious diseases using real patient problems (cases) and cases edited for educational purposes. This approach uses case studies to stimulate interactive learning and to facilitate basic knowledge for clinical training.
In seven sections, each problem in each section begins with a clinical case scenario and is followed by the learning objectives of the case. The "Question-and-answer" section facilitates student-tutor interaction, thereby resulting in a problem-solving approach. The etiological agent is then described in complete detail comprising the epidemiology and pathogenicity of the agent, and the host immune response, clinical manifestations, diagnostic, and therapeutic measures. This book includes a wide-spectrum of commonly encountered infectious diseases, emerging infectious diseases, and immunological diseases. This book caters to the need for fundamental knowledge through an alternative approach achieved by dividing the book into sections.
This book facilitates a more effective learning process thereby ensuring better information retention, correlation with real-life scenarios, and better applicability of the concepts.